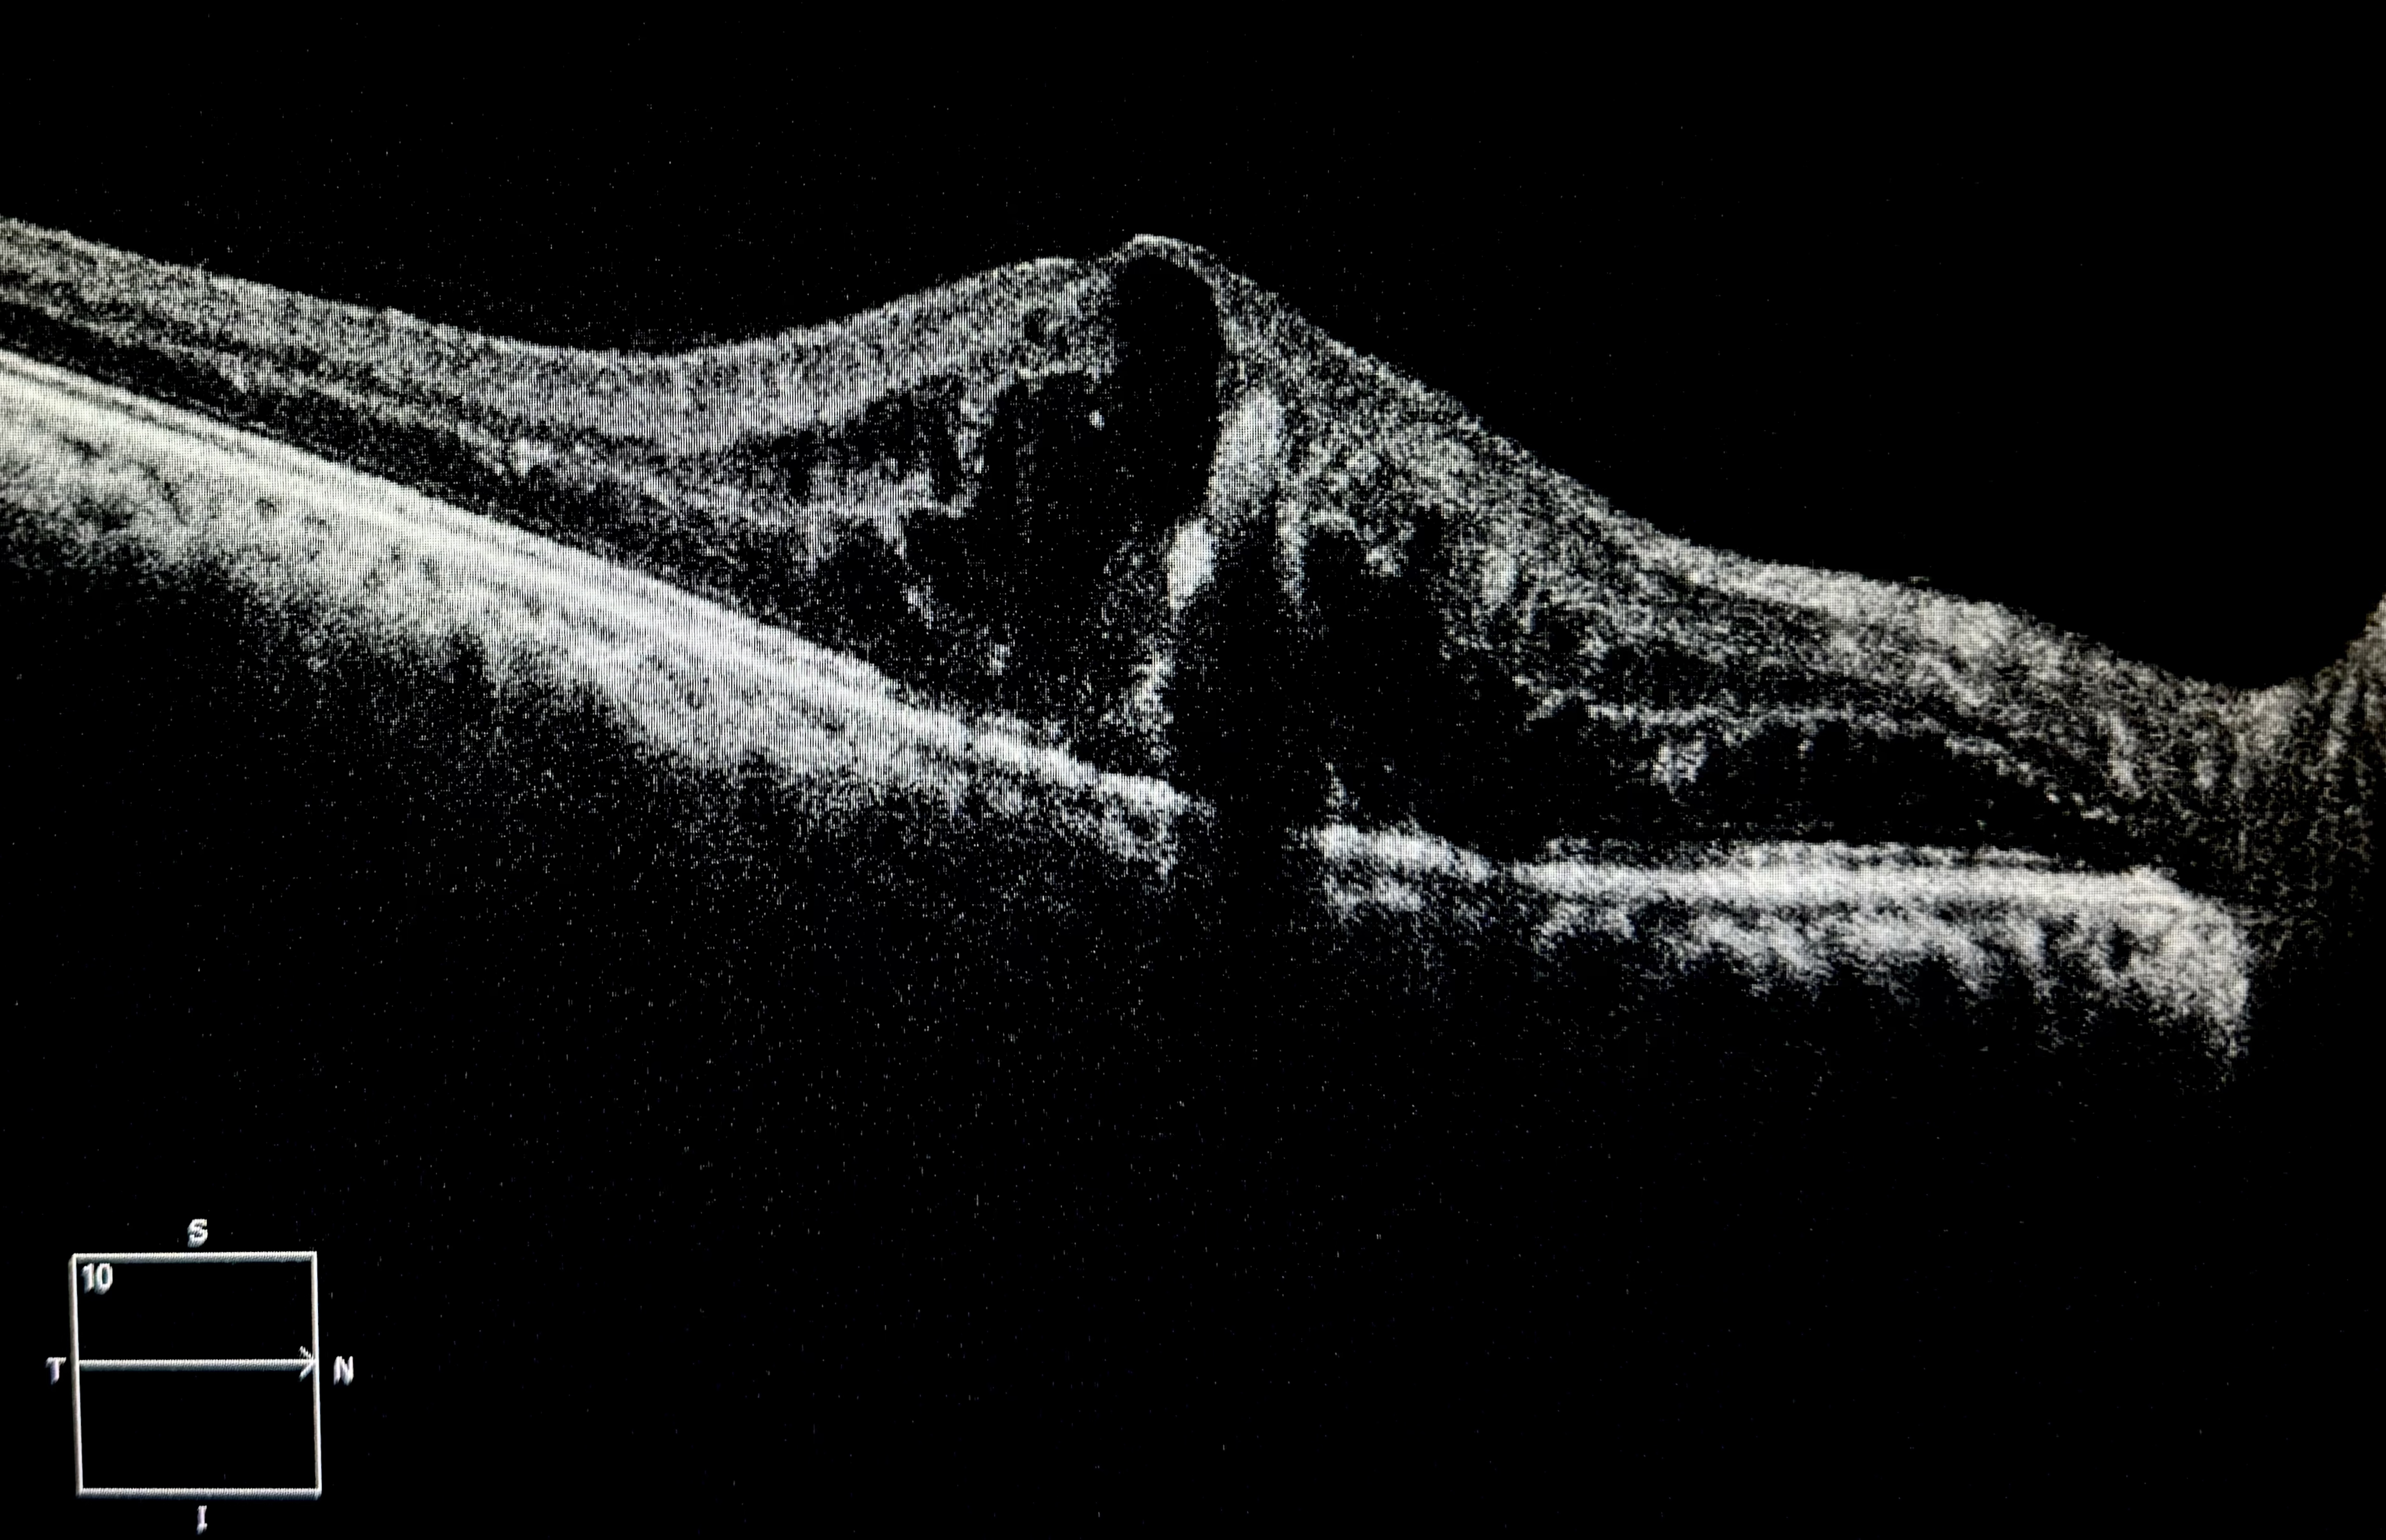
macroaneurysm

This Fundus Photo and OCT show preretinal hemorrhage due to a retinal arterial macroaneurysm rupture. Retinal macroaneurysms are focal dilations of the retinal arterioles, often associated with hypertension, arteriosclerosis, and other vascular diseases. They typically appear along the major temporal retinal arteries and may lead to hemorrhage, exudation, or retinal edema. OCT findings include hyper-reflective round lesions at the level of inner retina and intraretinal fluid. They can be managed conservatively through observation if are not active. For actively leaking aneurysms focal laser can be done. Intravitreal Anti-VEGFs are used as adjuvants in cases associated with intraretinal or subretinal fluid. Systemic control of Diabetes, Hypertension, and Cholesterol prevents recurrence and further vascular complications.
Credit: Dr. Aneri Shah Ambani
Insta ID: acoupleofeyesurgeons , aneri.shah.ambani
Institute: Core Vision – Eye Clinic, Ahmedabad, India